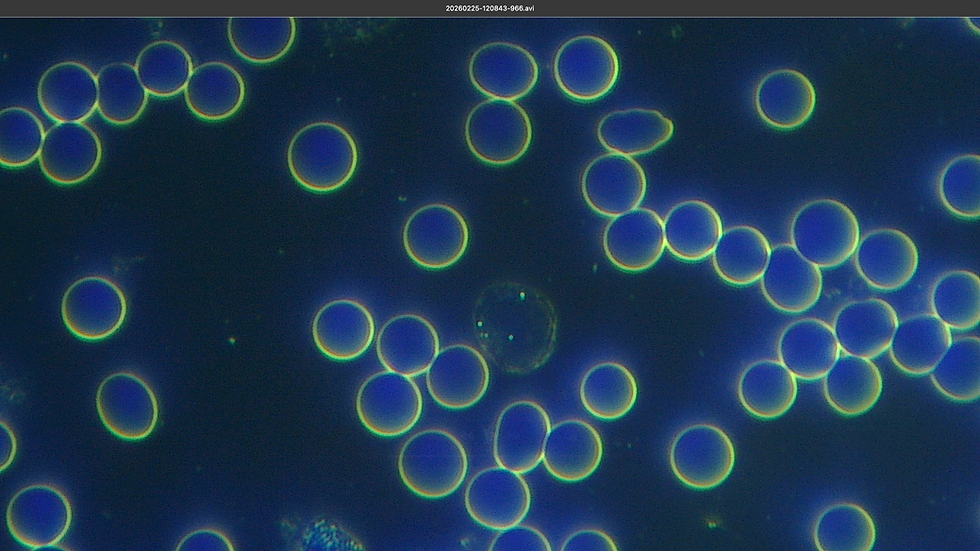
Captura de pantalla 2026-03-05 a la(s) 11.56.12 p.m..png

Research
Radiant Phi is an independent research and development laboratory dedicated to the exploration of advanced bioelectromagnetic technologies.
Our work focuses on the interaction between biological systems and structured electromagnetic fields, with particular attention to high-voltage and high-frequency environments capable of generating coherent electromagnetic conditions.
The laboratory designs, develops and engineers specialized systems used in therapeutic research and advanced bioelectromagnetic applications.
Radiant Phi integrates historical electrotherapy principles with modern engineering methodologies to expand the possibilities of electromagnetic interaction with biological systems.
Advanced Systems
Modular bioelectromagnetic research platforms.

GEO Compact
High-Voltage Bioelectromagnetic Generator
GEO Compact is a portable high-voltage generator designed for experimental bioelectromagnetic research and small-scale therapeutic environments.
The system produces structured electromagnetic fields under controlled laboratory conditions while maintaining the core architecture of the GEO platform.
GEO Plasma
Plasma Field Interaction System
GEO Plasma generates high-frequency plasma emissions used to study the interaction between ionized gases, electromagnetic fields and biological systems.
The system creates visible plasma environments capable of producing localized energetic conditions for advanced research.


GEO StarGate
Six-Plasma Resonant Electromagnetic Immersion System
GEO StarGate is an experimental system composed of six plasma tubes arranged around a large resonant coil designed to generate a spatial electromagnetic field environment around the human body.
The participant is positioned inside the central coil structure, effectively becoming the electromagnetic core of the system while high-voltage plasma emissions create a surrounding field environment.
A sliding treatment platform allows comfortable entry into the coil structure, while the coil assembly itself can be adjusted to precisely align with the center of the body.
Technology
RadiantPhi technologies are based on the generation of controlled electromagnetic field environments designed for advanced bioelectromagnetic research.
The laboratory develops systems capable of producing high-voltage and high-frequency electromagnetic conditions through resonant coil architectures, plasma emission systems and spatial field geometries.
These technologies allow the creation of structured electromagnetic environments capable of surrounding the human body and producing dynamic field interactions within biological systems.
Resonant Electromagnetic Fields
RadiantPhi systems employ resonant coil structures designed to generate spatial electromagnetic fields capable of interacting with biological electrical activity.
These resonant architectures enable the creation of coherent electromagnetic environments where field geometry and energy distribution can be precisely controlled and studied.
Plasma Emission Systems
Plasma emission technologies are used to produce visible ionized discharges and complex electromagnetic field dynamics.
These plasma environments provide a unique experimental platform for studying energetic field behavior and electromagnetic interactions in controlled conditions.
Spatial Field Structures
Certain RadiantPhi systems use large-scale electromagnetic structures capable of surrounding the human body with dynamic field configurations.
These spatial environments allow the study of full-body electromagnetic exposure and the interaction between structured fields and biological electrical processes.
Research Validation
Radiant Phi systems are evaluated through direct observation of biological, material, and electromagnetic response under controlled exposure conditions.
Our approach focuses on measurable changes in structure, field interaction, and system coherence, combining microscopy, spectral analysis, and real-world usage scenarios.
INITIAL state
%2012_16_30%E2%80%AFp_m__edited.jpg)
Dark field microscopy observation of erythrocyte morphology before electromagnetic exposure
%2011_56_12%E2%80%AFp_m_.png)
%2011_56_12%E2%80%AFp_m_.png)
POST EXPOSURE
Dark field microscopy observation of erythrocyte morphology after electromagnetic exposure
%2011_56_12%E2%80%AFp_m_.png)
Blood Morphology / Dark Field Observation
Three independent subjects with different clinical conditions were evaluated using dark field microscopy before and after exposure to structured electromagnetic environments.
Baseline observations revealed erythrocyte aggregation (rouleaux formation), reduced zeta potential, and impaired plasma conditions.
Following exposure (34–57 minutes), all cases demonstrated consistent changes:
-
Complete dispersion of erythrocytes
-
Restoration of cellular electrical charge
-
Increased plasma clarity and fluidity
These observations suggest a rapid interaction between electromagnetic field exposure and the electrical properties of blood.

Comparative analysis of multiple water samples under controlled conditions. The RadiantPhi-treated sample (blue) consistently exhibits distinct structural behavior across measured parameters.
INITIAL STATE
POST EXPOSURE
Dark field microscopy observation of erythrocyte morphology after electromagnetic exposure
Comparative analysis of multiple water samples under controlled conditions. The RadiantPhi-treated sample (blue) consistently exhibits distinct structural behavior across measured parameters.
Material Studies / Water Response
Radiant Phi systems are also evaluated through their interaction with physical substrates such as water.
Preliminary observations suggest structural modifications in liquid media exposed to high-frequency, high-voltage environments, indicating potential coherence effects at the molecular level.
These findings support the hypothesis that structured electromagnetic fields may influence not only biological systems, but also the organization and behavior of matter itself.

Emission spectroscopy across 9 tuning steps (taps), showing distinct spectral distributions at each configuration within the system’s operating range.
Spectral Analysis / Emission Profile
Radiant Phi systems are characterized through direct spectral observation of their electromagnetic emission.
The GEO Compact platform was measured under controlled conditions using spectrum analysis instrumentation and high-impedance probes within a shielded acquisition environment.
Across multiple output configurations, the system exhibits a coherent non-linear emission pattern organized through harmonic structures, rather than a fixed single-frequency output.
This behavior suggests a multipoint resonant system with dynamic interaction across its operating bandwidth.


Field Reports
The following reports reflect individual observations under specific usage conditions and protocols.
Outcomes may vary depending on biological response, duration of exposure, and application context.

Subject Report — Metabolic Condition
“After my first session with the StarGate MedBed, I noticed a rapid stabilization in my glucose levels. Over time, my system began to respond differently, as if it was recovering its internal balance.”
— Andrew, USA

Subject Report — Intensive Recovery Process
“Medical evaluations later showed a complete remission. Throughout the process, combining Radiant Phi sessions with complementary approaches, I experienced a profound shift in my condition and overall well-being.”
— Cristina Isabel, Mexico
Research Files
Selected technical documents and research records from ongoing system development.
Research Domains
Bioelectromagnetic technologies developed at Radiant Phi explore multiple areas related to the electrical nature of biological systems and electromagnetic field interaction.
Bioelectric Physiology
Certain RadiantPhi systems use large-scale electromagnetic structures capable of surroundingStudy of electrical processes regulating biological activity within living systems.
Cellular Resonance
Investigation of resonance phenomena between electromagnetic fields and cellular electrical structures.
Electromagnetic Therapeutics
Advanced development of electromagnetic environments designed for therapeutic applications.
Spatial Field Research
Study of large-scale electromagnetic field structures and their interaction with biological organisms.
Laboratory / Contact
Radiant Phi is an independent research laboratory focused on the development of bioelectromagnetic technologies and functional prototype systems.
The laboratory designs advanced platforms used for research, therapeutic exploration and the development of advanced electromagnetic technologies.
For collaborations, technical inquiries or system information: Contact Radiant Phi.









